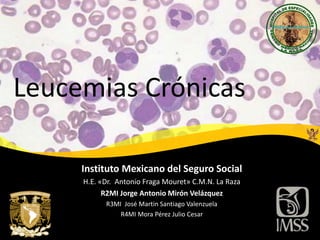

1) El documento describe la leucemia mieloide crónica (CML), incluyendo su definición, epidemiología, etiología, fisiopatología, cuadro clínico, diagnóstico y tratamiento.
2) La CML se caracteriza por la presencia del cromosoma de Filadelfia producto del translocación t(9;22) que genera la proteína de fusión BCR-ABL1.
3) El tratamiento de primera línea para la fase crónica es el uso de inhibidores de tirosina kinasa

![Fisiopatología
1- Afecta toda la
línea mieloide
2- 22q- [Ph]
3- G-6P DH
Kaushansky K. Williams Hematology; 9th edition McGraw Hill; 2016](https://image.slidesharecdn.com/aqwz3lqkr6mupwpniyoa-signature-088933d993e2b8824ecdd320bb92e5c9c63064a1bacd18ed8c8901faeb59070b-poli-191112034411/85/Leucemias-Cronicas-6-320.jpg)






![> 25 K/ μL
Hb
ADE
Pokilocitosis
Anisocitosis
WBC
Ret: N o
~50% >100 K/ μL
Kaushansky K. Williams Hematology; 9th edition McGraw Hill; 2016.
Sangre Periférica
Blástos ~3 % [hasta 10%]
Progranulocitos ~4%
Mielocitos,
Metamielocitos,
Bandas
~40%
Segmentados ~35%
Estudios de laboratorio: sangre
periférica](https://image.slidesharecdn.com/aqwz3lqkr6mupwpniyoa-signature-088933d993e2b8824ecdd320bb92e5c9c63064a1bacd18ed8c8901faeb59070b-poli-191112034411/85/Leucemias-Cronicas-13-320.jpg)

![Estudios de laboratorio: Citogenética
Cariotipo: Bandeo con Giemsa
• Ph - t(9;22)(q34;q11)(BCR-ABL1)
• 70% CML en F. crónica
• 20%- [t(Ph),-Y], 8 [t(Ph),+8], 9q+
[t(Ph), 22q-]
• 5% Cambios complejos
Kaushansky K. Williams Hematology; 9th edition McGraw Hill; 2016 / Hoffman R. HEMATOLOGY: Basic Principles and Practice; 6th ed Elsevier
Saunders; 2012
FISH
Traslocaciones inusuales e13a2 (b2a2) or e14a2 (b3a2)](https://image.slidesharecdn.com/aqwz3lqkr6mupwpniyoa-signature-088933d993e2b8824ecdd320bb92e5c9c63064a1bacd18ed8c8901faeb59070b-poli-191112034411/85/Leucemias-Cronicas-15-320.jpg)


![Estadificación: Riesgo
EURO score
Sokal Score
Sup. 2 años Sup. global
Sokal Bajo <0.8 90% 5 años
Intermedio 0.8-1.2 65-90% 2.5 a 5 años
Alto >1.2 65% 2.5 años
Sup. 5 años Sup. Global
EURO Bajo <781 76% 98 meses
Intermedio 781-1480 55% 65 meses
Alto >1480 25% 42 meses
Radich J. hronic myeloid leukemia, version 1.2019., Clinical practive guidlines in oncology. J Natl Compr Canc Netw 2018;16(9):1108–1135
[ 𝟏𝟏 ∗ 𝑬𝒅𝒂𝒅 + 𝟑𝟓 ∗ 𝑩𝒂𝒛𝒐 𝒄𝒎 (𝟖𝟗 ∗ 𝒃𝒍𝒂𝒔𝒕𝒐𝒔) + 𝟎. 𝟒 ∗ 𝑷𝑳𝑻 − 𝟓𝟓𝟎]
𝟏𝟎𝟎𝟎
[
0.666∗𝑒𝑑𝑎𝑑
0 𝑠í<50,1≥50
+ 0.042 ∗ 𝑏𝑎𝑧𝑜 (𝑐𝑚) + 0.0584 ∗ 𝑏𝑙𝑎𝑠𝑡𝑜𝑠 +
0.413 ∗ 𝐸𝑜𝑠. +
0.2039∗𝐵𝑎𝑠.
0 𝑠í<3%,1 𝑠í>3%
+
(1.0956∗𝑃𝐿𝑇)
0 𝑠í<150 𝐾,1 𝑠𝑖 ≥150𝐾
]*1000](https://image.slidesharecdn.com/aqwz3lqkr6mupwpniyoa-signature-088933d993e2b8824ecdd320bb92e5c9c63064a1bacd18ed8c8901faeb59070b-poli-191112034411/85/Leucemias-Cronicas-18-320.jpg)




![Polifarmacia
DOI 10.1182/blood-2010-07-294330
Imatinib: CYP 3A4, Excreción Biliar, 95% -albumina
Fármaco Efecto Recomendación
Ketoconazol,
itraconazol
Met., PpgT 40% [imitinib],
Citotoxicidad
Verapamilo, ICCa Met., PpgT Citotoxicidad,
[ICCa]
Eritromicina,
Claritromicina
Met., PpgT Citotoxicidad
Ciclosporina Met., PpgT Citotoxicidad
Rifampicina Met., PpgT Citotoxicidad
PPI Met., [Imitinib], SNC
Fármaco Efecto Recomendación
Fenitoina, Valproato,
Topiramato
Met. 74% [imitinib]
Rifampicina Met. 74% [imitinib]
Ranitidina hOCT1 [imitinib],
[intracelular]
Midazolam hOCT1 [imitinib],
[intracelular]
Levotiroxina Aclaramiento por no
desiodinización
[Tiroxina]
Acenocumarol CYP 2C9 x imatinib [Acenocumarol]](https://image.slidesharecdn.com/aqwz3lqkr6mupwpniyoa-signature-088933d993e2b8824ecdd320bb92e5c9c63064a1bacd18ed8c8901faeb59070b-poli-191112034411/85/Leucemias-Cronicas-23-320.jpg)
![Monitorización
• Normalización celular en FSP
• WBC <10K
• PLT <450K
• Sin C. inmaduras
• Asintomático, sin esplenomegalia
Hematologica
• CCyR – Sin Metafases con Ph+
• PCyR- 0-35% Ph+
• mCyR- >35% Ph+
Citogenetica - MO
• EMR ≤10% (IS) 3-6 Meses
• MMR ≤0.1% (IS) o reducción ≥ 3 Log de la línea de base [qPCR no disponible]
• CMR - MR 4.5
Respuesta molecular- [BCR-ABL1 mRNA] – qPCR [FSP/MO]
Radich J. hronic myeloid leukemia, version 1.2019., Clinical practive guidlines in oncology. J Natl Compr Canc Netw 2018;16(9):1108–1135](https://image.slidesharecdn.com/aqwz3lqkr6mupwpniyoa-signature-088933d993e2b8824ecdd320bb92e5c9c63064a1bacd18ed8c8901faeb59070b-poli-191112034411/85/Leucemias-Cronicas-24-320.jpg)

![Fallo al tratamiento
Radich J. hronic myeloid leukemia, version 1.2019., Clinical practive guidlines in oncology. J Natl Compr Canc Netw 2018;16(9):1108–1135
¿Adherencia?
Segunda línea
Dasatinib
Nilotinib
Imitinib [x2]
No respuesta 3,
6 o 12 meses
¿Resistencia ?
+ Omacetaxina [Resistencia a
≥ 2 TKI + T315I]
O
Trasplante alogenico CHT
Bosutinib
Ponatinib T315I](https://image.slidesharecdn.com/aqwz3lqkr6mupwpniyoa-signature-088933d993e2b8824ecdd320bb92e5c9c63064a1bacd18ed8c8901faeb59070b-poli-191112034411/85/Leucemias-Cronicas-26-320.jpg)

![Descontinuar tratamiento
Criterios de selección
≥ 18 años
Inicio temprano de la
terapéutica [CP-CML]
≥ MR 4 / ≥2 años
Acceso a qPCR (IS) –
Resultados ≤ 2 semanas
Monitorización:
Mensual/ 1 año
Semestral/ 2 año
Recaída
• Evidencia de cualquier signo
de recaída : hematológica o
citogenética
• 1 log BCR-ABL con
pérdida del MMR
• Reinicio de TKI / 4 sem
• Monitorizar:
– 4 semanas
– 3 meses
• Falla: Buscar mutaciones
Radich J. hronic myeloid leukemia, version 1.2019., Clinical practive guidlines in oncology. J Natl Compr Canc Netw 2018;16(9):1108–1135](https://image.slidesharecdn.com/aqwz3lqkr6mupwpniyoa-signature-088933d993e2b8824ecdd320bb92e5c9c63064a1bacd18ed8c8901faeb59070b-poli-191112034411/85/Leucemias-Cronicas-28-320.jpg)












![Presentación Clínica: Enfermedades
Autoinmunes
Anemia
Hemolítica
Autoinmue
Trombocitopenia
inmune
Aplasia de G.
Rojos Pura
Hallek M. Chronic lymphocytic leukemia: 2017 update on diagnosis, risk stratification, and treatment. Am J Hematol. 2017 Sep;92(9):946-965.
10-25% 1-5% <1%
CLL
[Linfocitosis]
CML
[Leucocitosis]](https://image.slidesharecdn.com/aqwz3lqkr6mupwpniyoa-signature-088933d993e2b8824ecdd320bb92e5c9c63064a1bacd18ed8c8901faeb59070b-poli-191112034411/85/Leucemias-Cronicas-41-320.jpg)
![Exploración física
Adenopatias
Esplenomegalia
Hepatomegalia leve
Hemorragias
Hemotórax / quilotorax
Ictericia/
Purpura [EAI]
Diarrea
crónica
SNC
Kipps T. Chronic lymphocytic leukaemia. Nat Rev Dis Primers. 2017 Jan 19; 3: 16096. Hoffman R. HEMATOLOGY: Basic Principles and Practice; 6th ed Elsevier
Saunders; 2012. Bairey O. Insect-bite-like reaction in patients with chronic lymphocytic leukemia: a study from the Israeli Chronic Lymphocytic Leukemia
Study Group. Eur J Haematol. 2012 Dec;89(6):491-6.
• Especificas - 8.3%
• No especificas – 45%
• Paraneoplasicas
• Reacción «Insect-
bite-like» -8.3%
Piel
Bairey et al 2012
IBLR N- 48 ---[14] 29 % Precede Dx](https://image.slidesharecdn.com/aqwz3lqkr6mupwpniyoa-signature-088933d993e2b8824ecdd320bb92e5c9c63064a1bacd18ed8c8901faeb59070b-poli-191112034411/85/Leucemias-Cronicas-42-320.jpg)
![Linfocitosis > 3.5K/uL
> 5K/uL– Cel. B [Citomero de flujo]
---The International Workshop on Chronic Lymphocytic
Leukaemia (IWCLL) -- 3 Meses
Hallazgos Paraclínicos
Kipps T. Chronic lymphocytic leukaemia. Nat Rev Dis Primers. 2017 Jan 19; 3: 16096. Hoffman R. HEMATOLOGY: Basic Principles and Practice; 6th
ed Elsevier Saunders; 2012
• Citometría Hemática
• Frotis
«Smudge Cell» Prolinfocitos <55%](https://image.slidesharecdn.com/aqwz3lqkr6mupwpniyoa-signature-088933d993e2b8824ecdd320bb92e5c9c63064a1bacd18ed8c8901faeb59070b-poli-191112034411/85/Leucemias-Cronicas-43-320.jpg)

![Diagnóstico
Hallek M. Chronic lymphocytic leukemia: 2017 update on diagnosis, risk stratification, and treatment. Am J Hematol. 2017 Sep;92(9):946-965.
Scarfò L. Chronic lymphocytic leukaemia. Crit Rev Oncol Hematol. 2016 Aug;104:169-82
The International Workshop on Chronic Lymphocytic Leukaemia (IWCLL) , 2008
Conteo de C. B >5K/uL
Citometría de Flujo
•Restricción de cadenas ligeras: λ o κ
•CD5
•CD23
•[] CD20, CD79b, Ig de superficie
3 meses
(+) Linfadenopatias/ Esplenomegalia SLL
(-) Linfadenopatias/ Esplenomegalia MBLLB < 5K/uL](https://image.slidesharecdn.com/aqwz3lqkr6mupwpniyoa-signature-088933d993e2b8824ecdd320bb92e5c9c63064a1bacd18ed8c8901faeb59070b-poli-191112034411/85/Leucemias-Cronicas-45-320.jpg)
![Estadificación - Pronóstico
Historia Natural de la Enfermedad
Anemia-Trombocitopenia
[2-3 años]
1/3 – Sin progresión
Variable
Variable
Hallek M. Chronic lymphocytic leukemia: 2017 update on diagnosis, risk stratification, and treatment. Am J Hematol. 2017 Sep;92(9):946-965.
Scarfò L. Chronic lymphocytic leukaemia. Crit Rev Oncol Hematol. 2016 Aug;104:169-82](https://image.slidesharecdn.com/aqwz3lqkr6mupwpniyoa-signature-088933d993e2b8824ecdd320bb92e5c9c63064a1bacd18ed8c8901faeb59070b-poli-191112034411/85/Leucemias-Cronicas-46-320.jpg)
![Estadificación
Estadio Características Supervivencia
0 Bajo Sólo linfocitosis en S.P. e infiltración de M.O. >150 meses
I Intermedio Linfoadenopatias 101 meses
II Hepatoesplenomegalia 71 meses
III Alto Anemia [<11g/dL] 19 meses
IV Trombocitopenia [<100 K/uL] 19 meses
Hallek M. Chronic lymphocytic leukemia: 2017 update on diagnosis, risk stratification, and treatment. Am J Hematol. 2017 Sep;92(9):946-965.
Scarfò L. Chronic lymphocytic leukaemia. Crit Rev Oncol Hematol. 2016 Aug;104:169-82
Sistema Rai
Estadio Características Supervivencia
A Sin anemia [Hb>10g/dL] ni trombocitopenia [PLT> 100K] y hasta 2 órganos
linfoides involucrados [Axilar, cervical, inguinal, bazo o hígado]
12 años
B Sin anemia [Hb>10g/dL] ni trombocitopenia [PLT> 100K] y > 2 órganos
linfoides involucrados
7 años
C Presencia de anemia [Hb>10g/dL] o trombocitopenia [PLT> 100K
Independientemente dela afectación linfoide
2 años
Sistema Binet](https://image.slidesharecdn.com/aqwz3lqkr6mupwpniyoa-signature-088933d993e2b8824ecdd320bb92e5c9c63064a1bacd18ed8c8901faeb59070b-poli-191112034411/85/Leucemias-Cronicas-47-320.jpg)

![LL International Prognostic Index (CLL-IPI)
Edad ≤ 65 años 0
>65 años +1
Estado clínico Binet A / Rai 0 0
Binet B-C/ Rai i-IV +1
Β2 – Microglobulina ≤3.5 mg/L 0
>3.5 mg/L +2
Mutación IGHV Mutado 0
No Mutado +2
TP53 Sin anormalidades 0
Del17p [FISH] o Mutación del TP53[Secuenciación] +4
Hallek M. Chronic lymphocytic leukemia: 2017 update on diagnosis, risk stratification, and treatment. Am J Hematol. 2017 Sep;92(9):946-965.
Scarfò L. Chronic lymphocytic leukaemia. Crit Rev Oncol Hematol. 2016 Aug;104:169-82
Puntaje Grupo Supervivencia a 5 años
0-1 Bajo riesgo 93.2%
2-3 Riesgo intermedio 79.3%
4-6 Alto riesgo 63.3%
7- 10 Muy alto riesgo 23.3%](https://image.slidesharecdn.com/aqwz3lqkr6mupwpniyoa-signature-088933d993e2b8824ecdd320bb92e5c9c63064a1bacd18ed8c8901faeb59070b-poli-191112034411/85/Leucemias-Cronicas-49-320.jpg)
![¿Cuándo iniciar tratamiento?
Criterios diagnósticos
Estadio Clínico: Rai: 0, Binet A , CLL-IPI LR o IR*
¿Sintomático? Sí
Iniciar Tratamiento
No
Vigilancia:
Fallo Medular[ Binet C o Rai III – IV]
Esplenomegalia masiva [>6 cm] o esplenomegalia progresiva y sintomática
Adenopatias masivas [>10cm]
IDT <6 meses
Linfocitosis progresiva, >50% en 2 meses
Mala respuesta a terapéutico sí se asocia a EAI
Síntomas B
iwCLL
Hallek M. Chronic lymphocytic leukemia: 2017 update on diagnosis, risk stratification, and treatment. Am J Hematol. 2017 Sep;92(9):946-965.
Scarfò L. Chronic lymphocytic leukaemia. Crit Rev Oncol Hematol. 2016 Aug;104:169-82](https://image.slidesharecdn.com/aqwz3lqkr6mupwpniyoa-signature-088933d993e2b8824ecdd320bb92e5c9c63064a1bacd18ed8c8901faeb59070b-poli-191112034411/85/Leucemias-Cronicas-50-320.jpg)


![Primera Línea
Estadio Condición Del (17p) o Mut.
P53
Terapia
Binet A-B,
Rao 0-II,
inactivo
Irrelevante Irrelevante Ninguna
Enfermedad
Activa o
Binett C o Rai
III - IV
«Go Go»
No
Fludarabina+Ciclofosfamida+Rituximab
(FCR) o Ibrutinib
Bendamustina + Rituximab (BR) [65%]
Sí
Ibrutanib, Idelalisib + Rituximab
TCT Alogenico
«Slow Go»
No
Clorambucil + Obinutuzumab (Ga-101)
+ Rituximab
+ Ofatumumab o Ibrutininb
Sí
Ibrutinib, Alemtuzumab, Altas dosis
Rituximab o Ofatumumab
Hallek M. Chronic lymphocytic leukemia: 2017 update on diagnosis, risk stratification, and treatment. Am J Hematol. 2017 Sep;92(9):946-965.
Scarfò L. Chronic lymphocytic leukaemia. Crit Rev Oncol Hematol. 2016 Aug;104:169-82](https://image.slidesharecdn.com/aqwz3lqkr6mupwpniyoa-signature-088933d993e2b8824ecdd320bb92e5c9c63064a1bacd18ed8c8901faeb59070b-poli-191112034411/85/Leucemias-Cronicas-53-320.jpg)
![Primera Línea
Estadio Condición Del (17p) o Mut.
P53
IGVH Terapia
Binet A-B,
Rao 0-II,
inactivo
Irrelevante Irrelevante I Ninguna
Enfermeda
d Activa o
Binett C o
Rai III - IV
«Go Go»
No
M
Fludarabina+Ciclofosfamida+Rituximab (FCR) o
Bendamustina + Rituximab (BR) [65 a]
NM
Ibrutinib o Fludarabina + Ciclofosfamida +
Rituximab (FCR) o Bendamustina + Rituximab
(BR) [65 a]
Sí I
Ibrutanib, Venetoclax o Idelalisib+ Rituximab
(contraindicado el ibrutinib)
«Slow Go»
No
M
Clorambucil + Obinutuzumab (Ga-101) o
Ibrutinib
NM Ibrutinib o Clorambucil +Obinutuzumab
Sí I
Ibrutinib o Venetoclax (+Obinutuumab) o
Idelalisib + rituximab (contraindicado el
ibrutinib)
Hallek M. Hematologic Malignancies: Chronic lymphocytic leukemia. Springer; 2019.](https://image.slidesharecdn.com/aqwz3lqkr6mupwpniyoa-signature-088933d993e2b8824ecdd320bb92e5c9c63064a1bacd18ed8c8901faeb59070b-poli-191112034411/85/Leucemias-Cronicas-54-320.jpg)





![Terapias Emergentes
Kipps T. Chronic lymphocytic leukaemia. Nat Rev Dis Primers. 2017 Jan 19; 3: 16096.
Mejora respuesta
inmune, [Ig]
Mielotoxicidad , Sd.
Tumor Doloroso, Sd. lisis
tumoral
Potencialmente
curativo. PLE / 5
años: 40-50%.
S.G 50-70%
Inmunosupresión](https://image.slidesharecdn.com/aqwz3lqkr6mupwpniyoa-signature-088933d993e2b8824ecdd320bb92e5c9c63064a1bacd18ed8c8901faeb59070b-poli-191112034411/85/Leucemias-Cronicas-60-320.jpg)
